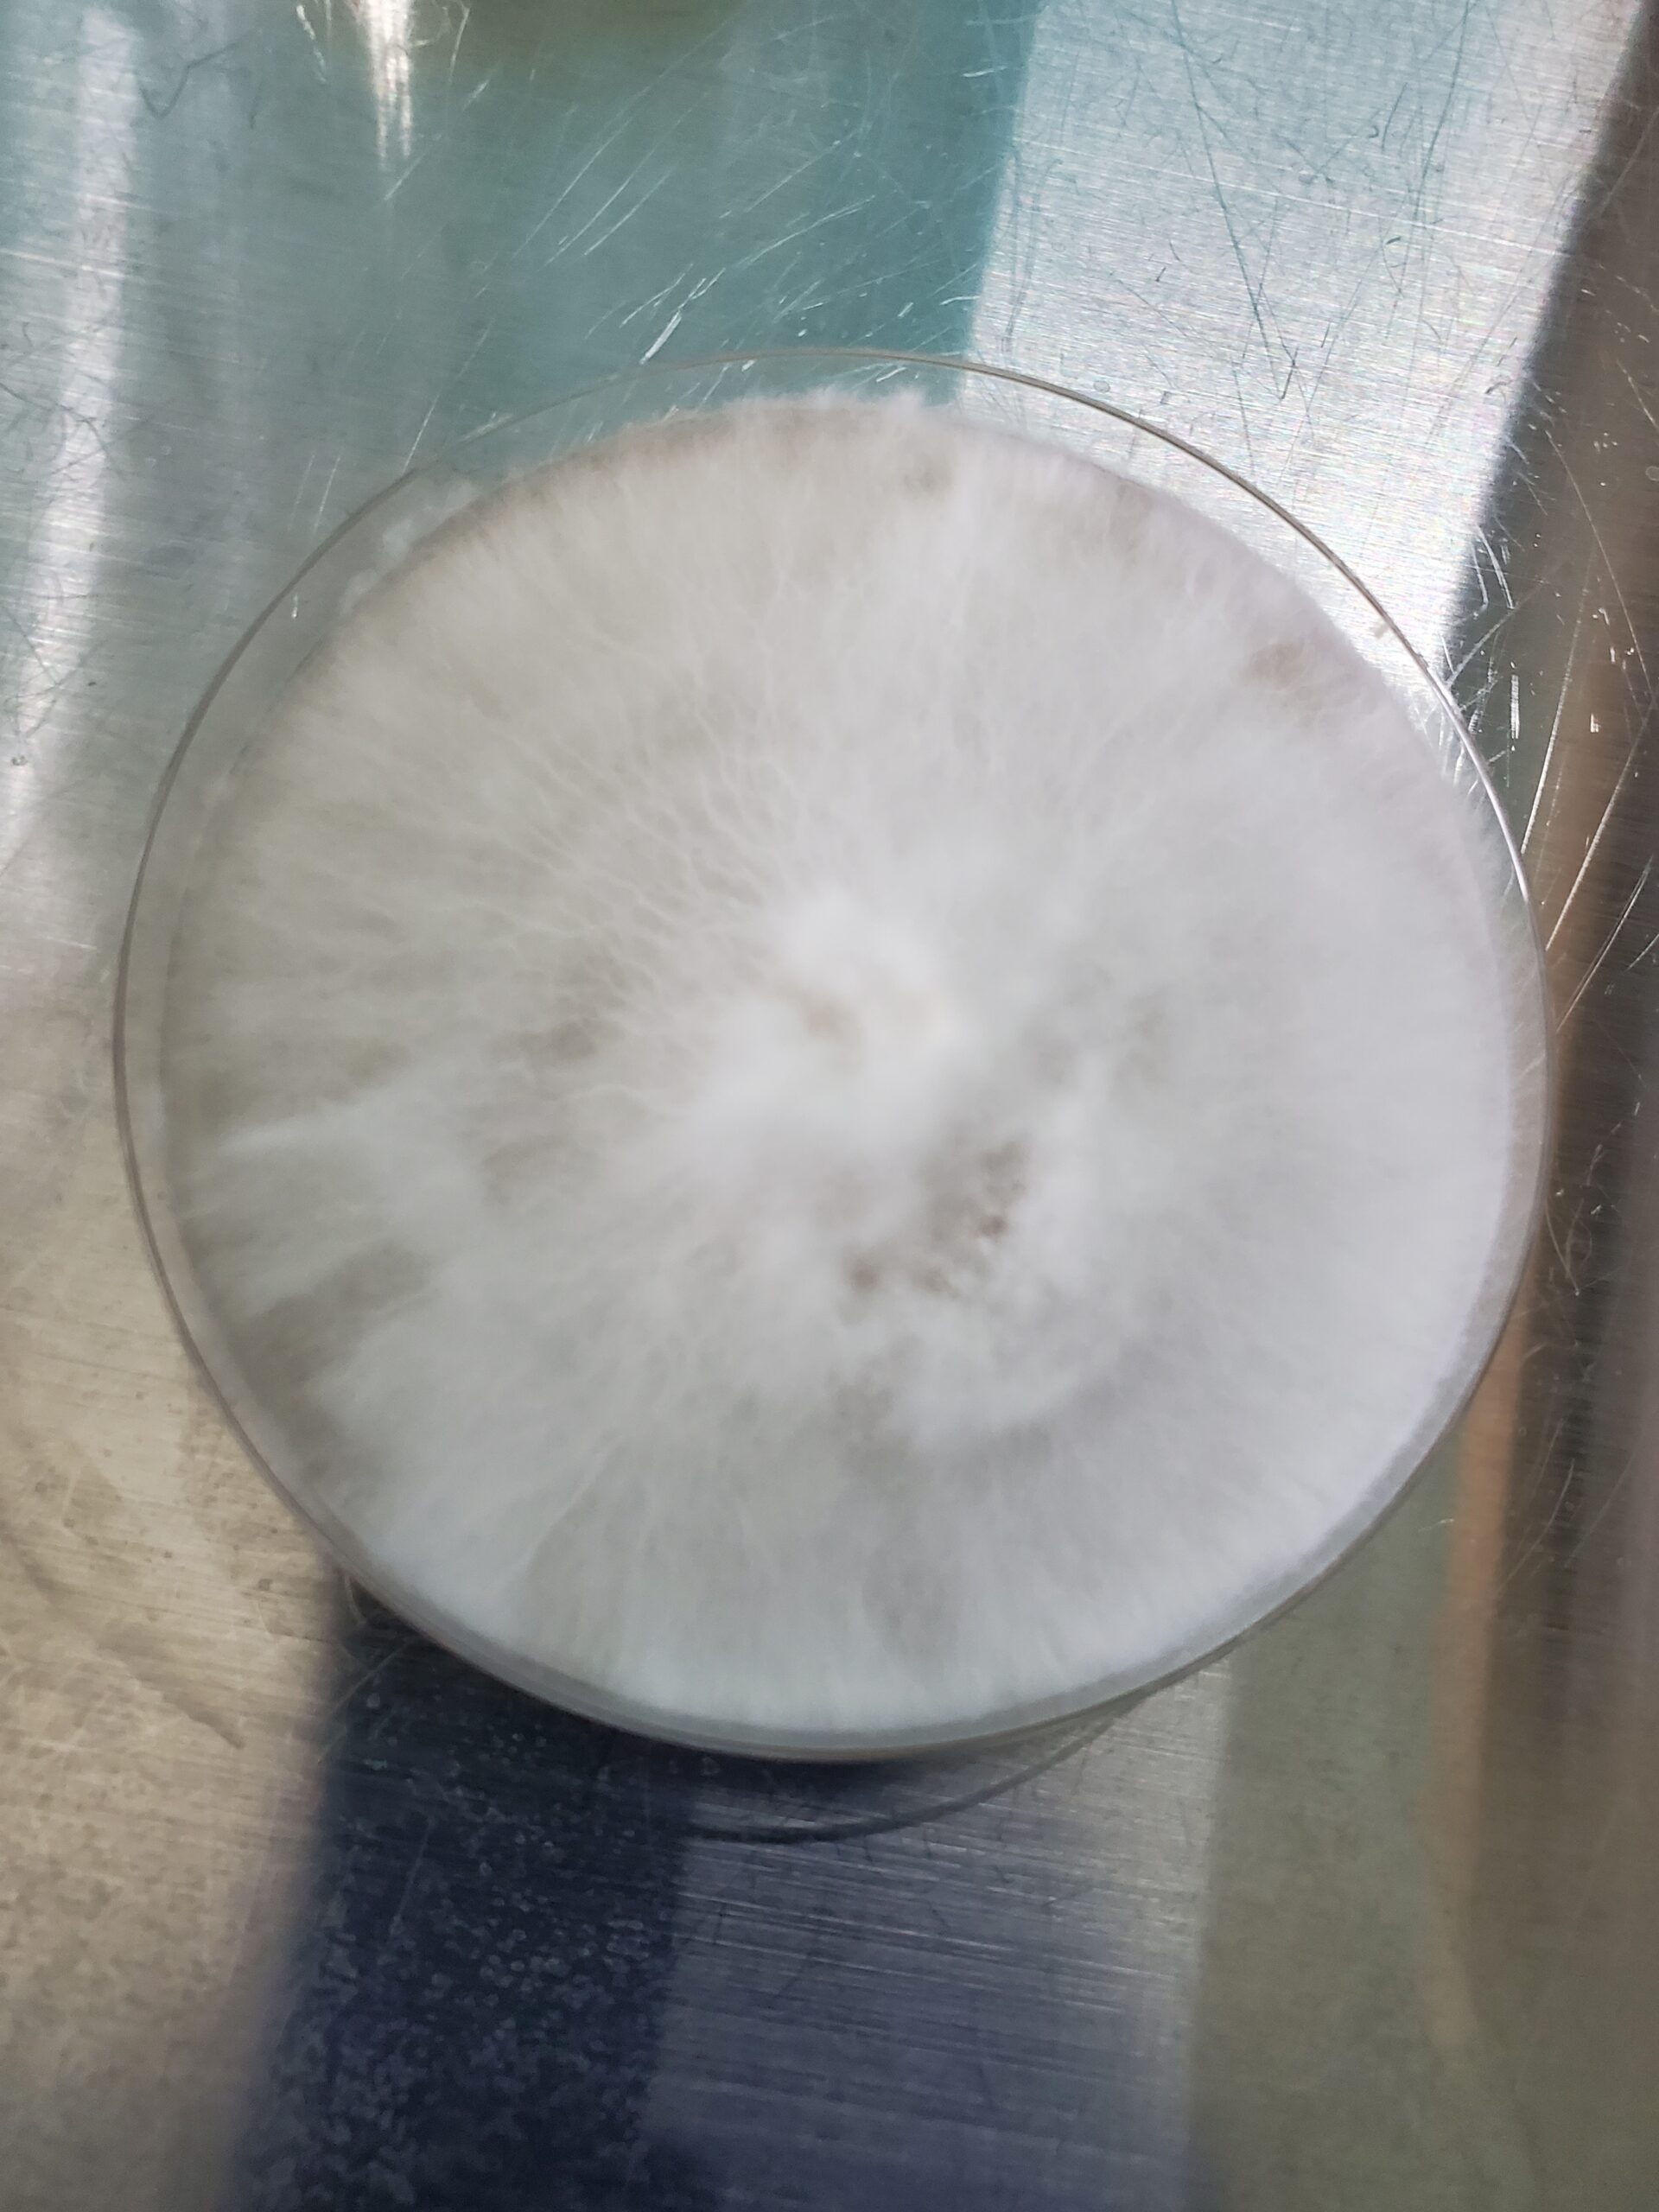

Only logged in customers who have purchased this product may leave a review.
PsyTeam United
Actives, Cultures
Steel Yeti Research Plate 100mm
$25.00
Psilocybe Cubensis
var. Steel Yeti
Steel Magnolia x Yeti
Steel Yeti is a very potent culture even for a cubensis hybrid, very aggressive body load but healing at the same time. Slightly slower than average grow times, about average in difficulty of growth. Very visual and strong couch lock but at the same time a racing mind and fast paced visuals. This strain effortlessly throws dense squatty fruits.
Units Sold: 3
Privacy Policy
Please refer to sporeswaps.com for the “Privacy Policy”.
Terms and Conditions
Please refer to sporeswaps.com for the “Terms & Conditions”.
Shipping costs
| Shipping from | United States (US) |
| Within United States (US) | $7.50 |
| Outside United States (US) | $20.00 |
National Shipping Details
| Minimum shipping charge per order | $7.50 |
| Maximum shipping charge per order | $7.50 |
| Free shipping if the order spend is over | $125.00 |
International Shipping Details
| Minimum shipping charge per order | $20.00 |
| Maximum shipping charge per order | $20.00 |
| Free shipping if the order spend is over | $250.00 |

Reviews
There are no reviews yet.